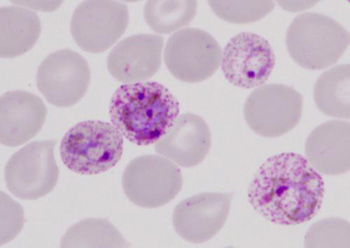

Tin bài nổi bật

Sốt rét dai dẳng, chữa thế nào?
Sốt rét dai dẳng thường do chủng loại ký sinh trùng sốt rét Plasmodium falciparum gây nên. Bệnh nhân bị mắc bệnh sốt rét lai rai, điều trị bảo đảm đúng liệu trình một đợt bằng thuốc đặc hiệu nhưng vẫn không sạch ký sinh trùng sốt rét và không cắt được cơn sốt. Nếu có cắt được sốt, vài ngày sau lại lên cơn sốt trở lại.
Sốt rét dai dẳng có hai loại khác nhau:
- Sốt rét dai dẳng kéo dài từ 7 đến 10 ngày trở lên, có khi tới 2 đến 3 tuần. Sử dụng hết đợt thuốc điều trị đặc hiệu vẫn không cắt được cơn sốt và không diệt sạch hết ký sinh trùng sốt rét.
- Sốt rét dai dẳng với biểu hiện lâm sàng có cơn sốt và xuất hiện ký sinh trùng sốt rét trong máu chỉ vài ngày, thường dưới 1 tuần rồi chấm dứt. Sau đó khoảng 7 ngày, ký sinh trùng sốt rét lại xuất hiện trở lại và gây nên sốt rét tái phát. Có trường hợp trong vòng khoảng một tháng, cơn sốt xảy ra tới 3 - 4 đợt.
Sốt rét dai dẳng thường dẫn đến hậu quả bệnh nhân bị thiếu máu, suy kiệt, teo cơ hoặc bệnh từ thể nhẹ chuyển sang thành thể nặng và có một số trường hợp bị sốt rét ác tính.
Nguyên nhân dẫn đến sốt rét dai dẳng
Sốt rét dai dẳng có thể do nhiều nguyên nhân khác nhau. Tùy theo nguyên nhân được phát hiện, chẩn đoán, sẽ có giải pháp chữa trị phù hợp. Có 3 trường hợp cần chú ý:
- Sốt rét dai dẳng do người bệnh bị nhiễm chủng loại ký sinh trùng sốt rét Plasmodium falciparum ký sinh trong máu nhưng ký sinh trùng đã kháng lại với loại thuốc đặc hiệu điều trị sốt rét đang sử dụng.
- Sốt rét dai dẳng xảy ra do liệu trình điều trị không đầy đủ nên thuốc không đủ hiệu lực diệt sạch hết ký sinh trùng sốt rét trong máu.
- Sốt rét dai dẳng cũng còn do bệnh nhân chưa có miễn dịch với bệnh sốt rét hoặc do người bệnh sốt rét có các bệnh khác kèm theo làm giảm sức đề kháng và khả năng tạo miễn dịch chống lại ký sinh trùng sốt rét.
Về điều trị
Để chữa khỏi sốt rét dai dẳng, cần xem xét, xác định các nguyên nhân đã nêu trên nhằm tìm biện pháp khắc phục. Cần sử dụng các loại thuốc điều trị sốt rét có hiệu lực cao để chống kháng, giám sát việc sử dụng thuốc của bệnh nhân theo đúng liệu trình quy định và khám phát hiện các bệnh khác kèm theo để chữa trị. Cụ thể bệnh nhân sốt rét do bị nhiễm ký sinh trùng sốt rét Plasmodium falciparum phải sử dụng thuốc dihydroartemisinine-piperaquine (biệt dược là arterakine hoặc CV artecan) dùng liều 3 ngày kết hợp với thuốc primaquine liều duy nhất cho tất cả các trường hợp có ký sinh trùng sốt rét dương tính. Nếu thất bại, có thể sử dụng thuốc điều trị thay thế như quinine dùng 7 ngày kết hợp với doxycycline dùng 7 ngày để giải quyết khả năng ký sinh trùng sốt rét đã kháng thuốc điều trị ưu tiên. Đối với trẻ em dưới 8 tuổi và phụ nữ có thai, sử dụng thuốc quinine 7 ngày kết hợp với thuốc clindamycine 7 ngày. Liều lượng dùng các loại thuốc theo hướng dẫn của phác đồ điều trị đã hướng dẫn.
Một điều cần lưu ý là bệnh nhân sốt rét được xác định đã điều trị khỏi bệnh và đáp ứng điều trị khi người bệnh hết các triệu chứng lâm sàng, sạch ký sinh trùng sốt rét sau 3 ngày điều trị và không có ký sinh trùng sốt rét trong suốt thời gian điều trị tính đến ngày thứ 28. Nếu kết quả xét nghiệm máu chỉ phát hiện được thể giao bào (gametocyte) mà người bệnh không sốt thì không phải là điều trị thất bại, trong trường hợp này cần sử dụng primaquine để diệt thể giao bào chống lây lan.
Tóm lại: thể bệnh sốt rét dai dẳng có thể điều trị khỏi, nó không phải là một bệnh kinh niên hay mạn tính như quan niệm của một số người bệnh chưa hiểu đúng về vấn đề này.
BS. Nguyễn Võ Hinh
Theo Suckhoedoisong
Thành viên đăng nhập

Sản phẩm bán chạy
Bộ kem trị nám Transino Nhật Bản được chứng nhận ở Nhật là có hiệu quả...
Platinum Hydro Whey là Protein tinh khiết được tạo ra bởi việc thủy phân Whey...
Hồng Sâm Tẩm Mật Ong Cắt Lát Sambok giúp chúng ta tỉnh táo hơn, khỏe mạnh...
Thực phẩm giảm cân 7-Day Slim có thành phần 100% thiên nhiên giúp làm giảm...
Viên Kẽm Chelated Zinc 50mg Puritan's Pride giúp tăng trưởng hormone sinh dục đồng...
Kem bôi trĩ chữ A của Nhật Bản giúp cho bạn giảm ngay lập tức sự khó chịu...
Chai xịt chống xuất tinh sớm Stud 100 giúp kéo dài thời gian quan hệ, ngăn chặn...
An cung ngưu hoàng hoàn Hàn Quốc hỗ trợ hoạt huyết điều hòa quá trình tuần...
Viên uống hỗ trợ trĩ Hemonase Nhật Bản giảm sưng đồng thời ngăn cho búi trĩ...
Trà Ngũ Diệp Sâm nay đối tên là Trà Cỏ Thần Kỳ được sản xuất 100% từ...
Sữa rửa mặt Kose Softymo Collagen chứa các tinh chất từ collagen cung cấp độ ẩm...
Serum Teana N1 chứa một hỗn hợp các hoạt chất giúp phục hồi cấu trúc của da...

Loading...
Quay lại